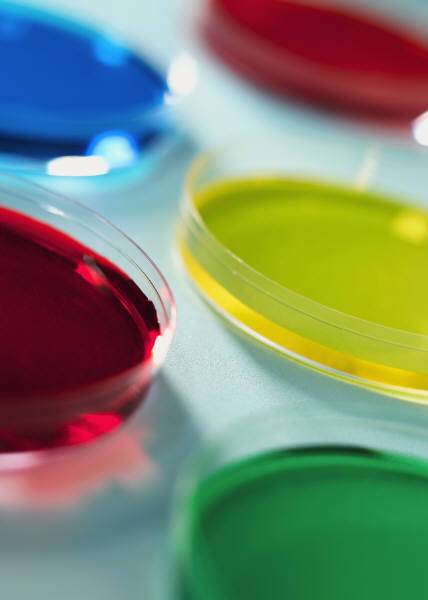

Image: ID 96660940 © Nipon Temsakun | Dreamstime.com
Words can be powerful. Nowhere is this more apparent to me than in Belgium, where I’m on the hunt for a new assignment. It’s proving challenging, but not because I lack the expert skills and experience of a transformation professional. Pas du tout!
In this tiny country, being trilingual is the norm. There are even secondary school education programmes where scientific subjects are taught in English, history in French and Maths in Dutch. Geweldig! I’ll wager good money that the average Belgian teenager speaks English and Dutch better than their UK counterparts.
It may sound like a cliche but Britons are the worst at learning other languages. In a recent survey by ESOL, 62% of people in the UK speak only English, and only 38% can make themselves understood in another tongue. Compare this to the 56% of Europeans who speak one other language, and the 28% who speak two! Half of EU citizens can hold a conversation in English.
At my level of seniority English is usually the business language of choice. Still, I feel at a disadvantage if I cannot express myself in fluent Dutch or French. I spent 6 months learning Dutch and practicing it as often as I can. It’s not perfect, but after 2 years I can describe what I do and how I do it and I’ve got to the point where Flemish Belgians do not switch automatically to English when they hear me speak, though they do make fun of my accent. I’m following an evening class in photography and make presentations in Dutch, so ‘ik spreek nederlands’. French is another story.
All of this has got me thinking about how important language is. Of course it’s possible to create cross-cultural rapport without the benefit of bilingualism, but somehow putting yourself in someone else’s shoes by being able to communicate in more than one language goes a long way – both personally and professionally. Shared vocabulary makes for greater connection, which is much needed in the digital echo-chamber we call work.
ID 73096510 © Promesaartstudio | Dreamstime.com